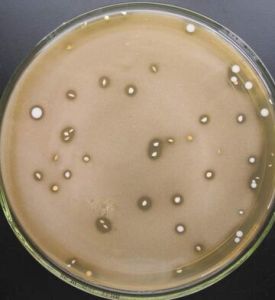
鑑別培養基

簡介
鑑別培養基幾種細菌由於對培養基中某一成分的分解能力不同,其菌落通過指示劑顯示不同的顏色而被區分開,這種起鑑別和區分不同細菌作用的培養基,叫鑑別培養基。
分類
鑑別培養基是用於鑑別不同類型微生物的培養基。在培養基中加入某種特殊化學物質,鑑別培養基主要用於微生物的快速分類鑑定,以及分離和篩選產生某種代謝產物的微生物菌種。常用的一些鑑別培養基參見表。
| 培養基名稱 | 加入化學物質 | 微生物代謝產物 | 培養基特徵性變化 | 主要用途 |
| 酪素培養基 | 酪素 | 胞外蛋白酶 | 蛋白水解圈 | 鑑別產蛋白酶菌株 |
| 明膠培養基 | 明膠 | 胞外蛋白酶 | 明膠液化 | 鑑別產蛋白酶菌株 |
| 油脂培養基 | 油脂、土溫、中性紅指示劑 | 胞外脂肪酶 | 由淡紅色變成深紅色 | 鑑別產脂肪酶菌株 |
| 澱粉培養基 | 可溶性澱粉 | 胞外澱粉酶 | 澱粉水解圈 | 鑑別產澱粉酶菌株 |
| H2S試驗培養基 | 醋酸鉛 | H2S | 產生黑色沉澱 | 鑑別產H2S菌株 |
| 糖發酵培養基 | 溴甲酚紫 | 乳酸、醋酸、丙酸等 | 由紫色變成黃色 | 鑑別腸道細菌 |
| 遠藤氏培養基 | 鹼性復紅、亞硫酸鈉 | 酸、乙醛 | 帶金屬光澤深紅色菌落 | 鑑別水中大腸菌群 |
| 伊紅美藍培養基 | 伊紅、美藍 | 酸 | 帶金屬光澤深紫色菌落 | 鑑別水中大腸菌群 |